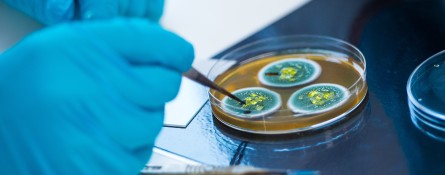

Research courses
Learn more about postgraduate research opportunities at the School of Biosciences, which is home to a vibrant research community. Our extensive, well-established collaborations with industry provide knowledge transfer to the commercial sector and the wider community.
Find a course
Find out more about applying to Surrey.
Studentships
Joint University of Surrey and A*STAR PhD studentships
Funding information:
Whilst the candidate is in the UK, University of Surrey funding will include UKRI-aligned stipend (£17,668 pa for 2025-6) and approved fees. When the candidate relocates to Singapore, A*STAR will provide funding consisting of: a stipend of SGD 3600/month, housing subsidy of SGD300/month, a one-time airfare grant to Singapore of SGD 1,500, a one-time settling-in allowance in Singapore of SGD 1,000, a one-time IT allowance of SGD 800, medical insurance and a conference allowance. Please note that the Surrey stipend will cease while the student is based in Singapore.Expert support
The Doctoral College supports the academic and professional development of postgraduate researchers to ensure our world-leading research continues to grow. There is also an extensive Researcher Development Programme run at university level.
What our students say
Read our student profiles to discover first-hand what it's like to study with us.
World-class facilities
Our School is home to specialist facilities that provide the latest technologies to support research across all fields.